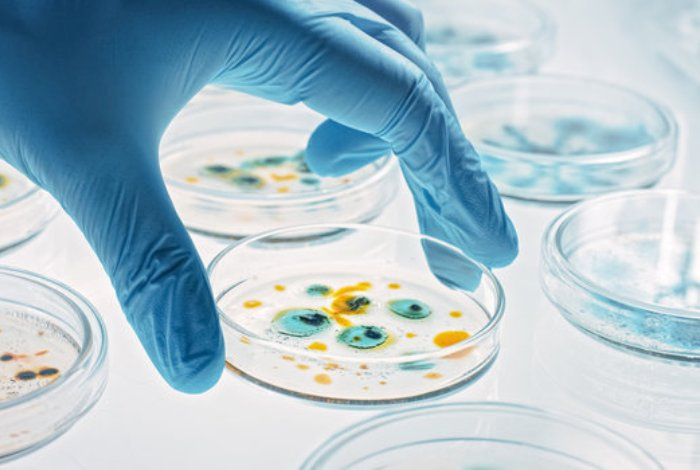

7 месяцев назад
Ученые предупреждают, что к 2050 году более 39 миллионов человек могут погибнуть из-за супербактерий, устойчивых к лекарствам, передает Sports.kz со ссылкой на «СЭ».